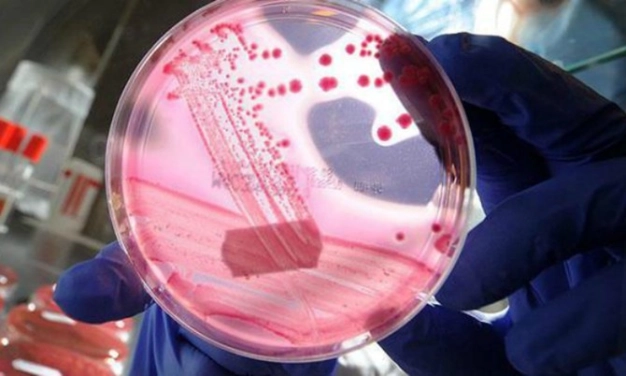
Kanserin yayılmasına yol açan hücre bulundu

Belçikalı araştırmacılar, kanserinmetastaz yapmasına yol açan tümör hücrelerini belirledi. Özgür Brüksel Üniversitesi (ULB), Katolik Leuven Üniversitesi ve Erasmus Hastanesi’nden 25 doktor, araştırmayı Avrupa Birliği (AB) fonlarıyla cilt ve göğüs kanserini temel alarak yaptı.Prof. Dr. Cedric Blanpain’in yönettiği araştırmada bilim adamları,kanserin farklı evrelerindeki hücreleri inceledi vekötü huylu olanları 6 ayrı kategoriye ayırdı.
Tümörhücrelerinin genetik yapısını inceleyen araştırmacılar, bilinenin aksine bu hücrelerin birbirleriyle aynı olmadığını, kanserin köken aldığı organın dışına çıkarak diğer dokulara yayılmasına neden olan kötü huylu hücrelerin bazı farklılıklar gösterdiğini tespit etti.
Araştırmada elde edilensonuçların, kanser tedavisinin kesinlik derecesini artırabileceğine,metastaza yol açan hücrenin belirlenmesiyle tedavidehedefin daha belirgin hale geleceğine işaret edildi.